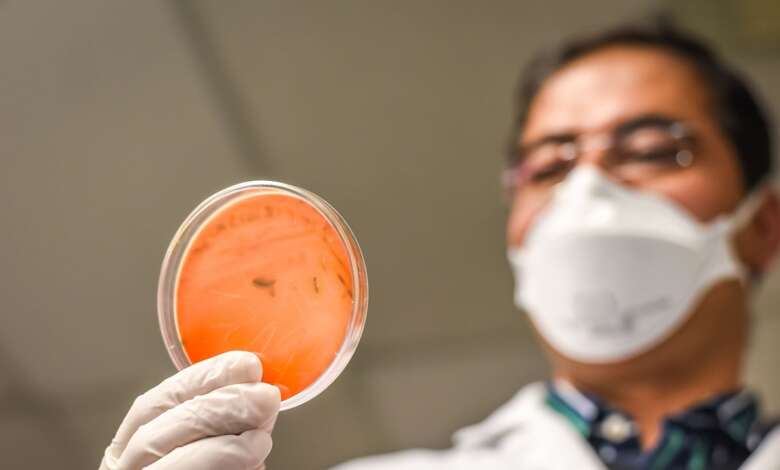

Programme SANOI : La sécurité alimentaire et nutritionnelle au cœur d’un atelier régional
Pendant trois jours, les laborantins mauriciens et ceux de la région se sont réuni à l’hôtel Le Labourdonnais Waterfront à Port-Louis pour un atelier sur les politiques de laboratoires et le renforcement de leurs capacités. Ce programme d’appui à la Sécurité Alimentaire et Nutritionnelle dans l’océan Indien (SANOI) est organisé par la Commission de l’océan Indien (COI) et soutenu par l’Union européenne.
« Nourrir durablement l’Indianocéanie ». Tel est le slogan du projet SANOI et dont un atelier régional a eu lieu du 14 au 16 juin à Maurice. Organisé dans le cadre du programme régional d’appui à la Sécurité Alimentaire et Nutritionnelle (SANOI), financé par l’Union européenne et mis en œuvre en partenariat avec la COI, cet atelier a accueilli une vingtaine de représentants de laboratoires des Comores, de Madagascar, des Seychelles et de Maurice.

Pour la COI, l’objectif principal de l’atelier est de fournir un espace d’échanges techniques aux principaux acteurs du domaine de l’analyse alimentaire avec un focus « sécurité sanitaire des aliments » et de faire un état des lieux de la situation sanitaire et phyto- sanitaire dans l’océan Indien, en vue d’identifier les enjeux et défis régionaux.
L’atelier devait permettre aux représentants des laboratoires d’avoir des échanges techniques autour de trois axes notamment la création d’un réseau des principaux acteurs du domaine de l’analyse alimentaire dans la région et de faire un état des lieux de la situation sanitaire et phyto- sanitaire dans l’océan Indien. Ensuite, le troisième axe comprend l’élaboration d’un inventaire détaillé des compétences et capacités existantes dans la région en matière d’analyses des aliments.
Lors de la cérémonie d’ouverture tenue le mardi 13 juin à l’hôtel Le Labourdonnais, l’ambassadeur de l’Union européenne, Vincent Degert a parlé notamment de l’importance de la sécurité sanitaire des aliments, qui demeure un problème commun. « La sécurité sanitaire des aliments doit être garantie à chaque étape de la chaîne d’approvisionnement. Cette sécurité sanitaire est souvent tenue pour acquise. Elle est pourtant à l’origine de problèmes de santé majeurs et source de pertes économiques considérables. Selon l’Organisation mondiale de la Santé, chaque année, près d’une personne sur dix dans le monde tombe malade après avoir ingéré des aliments contaminés et plus de 400 000 personnes meurent chaque année à cause des maladies d’origine alimentaire, dont un tiers d’enfants. Tous les pays sont concernés », a souligné Vincent Degert.
Pour le Secrétaire général de la COI qui a également intervenu par vidéoconférence des Comores, cet atelier a permis de jeter les premiers jalons pour apporter une réponse commune et adaptée, en s’appuyant sur une coopération renforcée entre les différents acteurs, à commencer par les laboratoires et une optimisation des moyens disponibles.
« Les laboratoires représentent un maillon essentiel du dispositif de surveillance et de contrôle visant à garantir la sécurité sanitaire des aliments. A travers le programme SANOI, c’est un appui concret qui sera fourni aux laboratoires des pays de la région pour renforcer leurs capacités à travers des formations aux méthodes d’analyse, des formations à la maintenance des équipements ou des appuis pour l’obtention de certification », a ajouté Vincent Degert.
Lutter contre la malnutrition
D’une durée de 5 ans (mars 2020 à mars 2025), le programme SANOI a pour objectif de réduire la malnutrition et l’insécurité alimentaire dans la région de l’océan Indien, particulièrement pour les enfants âgés de 0 à 5 ans et les femmes enceintes. Le programme a quatre composantes et la première est de promouvoir des pratiques agricoles durables et adaptées au changement climatique. Ensuite, il y va d’accompagner la diversification de l’alimentation des populations vulnérables à travers des campagnes de sensibilisation. Les deux autres composantes sont notamment de renforcer la sécurité sanitaire des produits agricoles au niveau régional et d’améliorer l’information sur la sécurité alimentaire et nutritionnelle au niveau de chaque pays.




